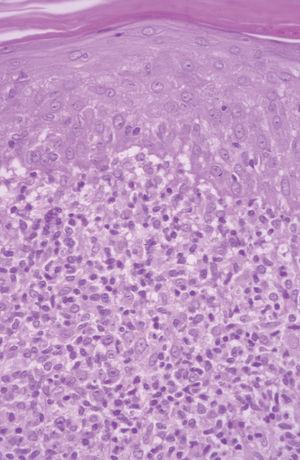

INTRODUCCION
Los fármacos antiepilépticos, especialmente la fenitoína y la carbamazepina pueden producir casos de seudolinfomas. La carbamazepina se utiliza fundamentalmente para tratar la epilepsia, trastornos asociados al dolor como la neuralgia del trigémino y las enfermedades psiquiátricas con alteraciones afectivas. La toxicidad extracutánea de la carbamazepina es fundamentalmente neuropsiquiátrica (vértigo, ataxia, cefalea, diplopía), hematológica (leucopenia y anemia) y hepática (habitualmente alteraciones analíticas que pueden producir de manera excepcional hepatitis o fallo hepático). Aproximadamente el 3-8 % de los pacientes que toman carbamazepina desarrollan enfermedades cutáneas, algunas de ellas similares a la micosis fungoide 1-4. Además de seudolinfomas se han descrito múltiples efectos secundarios en la piel como enfermedades ampollosas 5, fotosensibilidad 6, necrolisis epidérmica tóxica 7, pustulosis exantemática 8 y dermatitis exfoliativa 9, entre otras.
Los seudolinfomas inducidos por carbamazepina presentan un amplio espectro clínico que se puede encuadrar en dos patrones diferentes. El primero estaría representado por casos con lesiones cutáneas que aparecen de manera tardía, únicas o en escaso número, en forma de placas infiltradas o nódulos persistentes y sin síntomas generales ni fallo multiorgánico. Las lesiones pueden persistir en ocasiones después de suspender la medicación e incluso puede haber un reordenamiento positivo. El segundo patrón tendría una clínica semejante a la de un síndrome de hipersensibilidad por fármacos, con un inicio más precoz, síntomas generales y afectación multiorgánica 10.
El curso de los seudolinfomas suele ser autoinvolutivo con la suspensión del fármaco implicado, pero el diagnóstico diferencial en ocasiones resulta dificultoso. Presentamos 3 casos de seudolinfomas cutáneos inducidos por carbamazepina con presentaciones clínicas diferentes.
DESCRIPCION DE LOS CASOS
Caso 1
Un varón de 50 años había iniciado 4 años atrás, tratamiento con carbamazepina por una epilepsia secundaria a un accidente cerebrovascular. Un año después del inicio del tratamiento desarrolló una lesión en placa eritematosa infiltrada en el área preesternal y un año más tarde apareció otra lesión similar en la región pectoral derecha. Las lesiones eran asintomáticas y aumentaban lentamente de tamaño. A la exploración física presentaba dos lesiones en forma de placas eritematosas infiltradas con un diámetro de 3 y 1,5 cm, respectivamente, en la región preesternal y pectoral derecha (fig. 1). No se palpaban adenopatías, ni visceromegalias. El estudio histopatológico mostraba un denso infiltrado en la banda linfocitaria en la dermis superior con linfocitos pequeños de núcleo irregular (fig. 2). También existía epidermotropismo y queratinocitos necróticos en la epidermis. El reordenamiento del gen del receptor de células T (TCR) en piel fue negativo. Los estudios de laboratorio demostraron como única alteración una hipogammaglobulinemia. Las pruebas epicutáneas fueron negativas. Las lesiones desaparecieron progresivamente con la suspensión del fármaco en 4 meses.
Fig. 1.--Caso 1. Placa eritematosa en el área preesternal.
Fig. 2.--Caso 1. Infiltrado en banda linfocitario en dermis superior con linfocíticos atípicos de pequeño tamaño que infiltran la epidermis. Queratinocitos necróticos. (Hematoxilina-eosina, x200.)
Caso 2
Una mujer de 42 años desarrolló múltiples lesiones maculopapulosas pruriginosas en el tronco y las extremidades 7 días después de iniciar un tratamiento con carbamazepina por una neuralgia del trigémino. A la exploración física presentaba lesiones maculopapulosas, eritematosas, no confluentes, bien limitadas con un diámetro aproximado de entre 0,5 y 2 cm en axilas, tronco, ingles y muslos (fig. 3). No presentaba adenopatías ni visceromegalias. La biopsia cutánea mostraba una epidermis con hiperqueratosis e hiperplasia psoriasiforme con un marcado epidermotropismo de linfocitos atípicos con núcleos hipercromáticos (fig. 4). No se pudo realizar el reordenamiento en piel por falta de material. Los análisis mostraron una hipercolesterolemia con ligera hipertransaminemia sin otras alteraciones. No se realizaron pruebas epicutáneas. Las lesiones se resolvieron en un mes sin tratamiento, tras a retirada de la carbamazepina.
Fig. 3.--Caso 2. Lesiones eritematosas maculopapulosas en extremidades inferiores.
Fig. 4.--Caso 2. Epidermotropismo de linfocitos atípicos de pequeño tamaño y microabscesos simulando una micosis fungoide. (Hematoxilina-eosina, x400.)
Caso 3
Un varón de 25 años, sin historia previa de enfermedad cutánea y en tratamiento con carbamazepina por crisis epilépticas como secuela de un accidente de tráfico, desarrolló, un mes después del inicio de la terapia, un cuadro cutáneo que se acompañaba de fiebre y múltiples lesiones maculopapulosas eritematosas con tendencia a confluir, infiltradas y con un diámetro entre 0,5 y 2 cm en casi la totalidad de la superficie corporal, incluidas las palmas y las plantas (fig. 5). También presentaba edema facial (más intenso en la región periorbitaria) y pústulas foliculares en la nariz y mejillas. Los resultados analíticos mostraban unos valores de leucocitos de 11.680 cél./μl con el 12 % de eosinófilos, aumento de las enzimas hepáticas GPT 647 U/l, GOT 230 U/l y GGT 262 U/l. No presentaba adenopatías ni visceromegalias. En el Servicio de Urgencias se suspendió la carbamazepina y se inició un tratamiento con ácido valproico. Los hallazgos histopatológicos demostraban una discreta hiperplasia psoriasiforme y en la dermis superficial se apreciaban ligeros infiltrados constituidos por linfocitos, algunos de ellos de tamaño intermedio y núcleo hipercromático. Ocasionalmente se identificaron agrupaciones linfocitarias semejantes a microabscesos de Pautrier (fig. 6). El reordenamiento del gen del TCR en la piel fue negativo. Las pruebas epicutáneas se realizaron 3 meses después de la erupción utilizando concentraciones al 1 y al 5 % en vaselina y ambas fueron positivas. Las lesiones desaparecieron progresivamente en un mes con tratamiento con corticoides sistémicos con una dosis inicial de 1 mg/kg/día.
Fig. 5.--Caso 3. Lesiones maculopapulosas eritematosas infiltradas.
Fig. 6.--Caso 3. Epidermotropismo con infiltrado de linfocitos atípicos en la epidermis formando microabscesos de Pautrier. (Hematoxilina-eosina, x400.)
DISCUSION
Aunque Callot et al 11 intentaron diferenciar el seudolinfoma y el síndrome de hipersensibilidad, hoy en día no existe una definición consensuada del seudolinfoma inducido por drogas. El término se utiliza de manera indistinta para describir erupciones que histológicamente simulan linfomas cutáneos y cuadros definidos anteriormente como síndrome de hipersensibilidad. Cerroni et al 12 distinguen dos patrones clínico-patológicos en los seudolinfomas inducidos por fármacos. Por un lado, se encuentran aquéllos con patrón de seudolinfoma B (lesiones nodulares solitarias o en escaso número) y aquéllos con patrón de seudolinfoma T, similares a los casos de nuestra serie.
Nuestros pacientes tenían como hecho en común el patrón histológico tipo micosis fungoide. En el primer caso existía un denso infiltrado en banda de linfocitos pequeños en la dermis superficial con un epidermotropismo focal. Sin embargo, tanto en el segundo como en el tercer caso, se apreciaba mayor epidermotropismo con linfocitos atípicos de mayor tamaño y núcleo irregular que histológicamente recuerdan a la micosis fungoide.
Recientemente se ha realizado un estudio clinicopatológico y genotípico en 8 casos de seudolinfomas inducidos por anticonvulsivos 13. Las similitudes entre los seudolinfomas y las micosis fungoides fueron el epidermotropismo de linfocitos atípicos (100 %) y los microabscesos de Pautrier en el 38 %. Sin embargo, como hecho diferenciador en los seudolinfomas, existe una espongiosis que puede ser desde moderada a marcada (75 %), queratinocitos necróticos (63 %), infiltración de eosinófilos en la epidermis (25 %), edema de la dermis papilar (100 %), eritrocitos extravasados (100 %), linfocitos en la dermis mayores que aquellos que están en la epidermis (63 %) e infiltración de varias células inflamatorias incluyendo neutrófilos (50 %).
La presentación clínica de nuestros casos era muy diferente entre sí. En el primer caso el cuadro clínico recordaba una micosis fungoide clásica en estadio de placa, que se había iniciado mucho después de iniciar el tratamiento con carbamazepina. No existían datos de afectación sistémica y el cuadro clínico regresó al suspender el fármaco. El tercer caso correspondía clínicamente a un síndrome de hipersensibilidad típico con erupción cutánea, fiebre, adenopatías, eosinofilia, linfocitos atípicos e hipertransaminasemia. Además, presentaba edema facial y pústulas en la cara que se han considerado como típicos de este síndrome.
En nuestros pacientes la relación temporal entre las lesiones cutáneas y la utilización de la carbamazepina y la falta de recurrencia de las lesiones después de un tiempo de seguimiento prolongado (8, 7 y 2 años, respectivamente, para los casos 1, 2 y 3), sugieren con claridad el diagnóstico de seudolinfoma inducido por fármacos más que una resolución espontánea de un verdadero linfoma.
Las pruebas epicutáneas fueron negativas en el primer caso y positivas en el tercero. El porcentaje de pruebas epicutáneas positivas para la carbamazepina en la literatura médica va desde el 24 al 100 % 14. Incluso cuando las pruebas epicutáneas para demostrar que un fármaco está implicado en un cuadro cutáneo se realizan con el consenso de los expertos, el resultado es negativo en el 30-50 % de los pacientes, por lo que un resultado negativo no excluye la responsabilidad de un fármaco 15. Los resultados negativos pueden tener diferentes explicaciones: que el agente responsable de la reacción sea un metabolito que no se forme en la piel, que no exista un mecanismo inmunitario implicado en la reacción o que los factores concomitantes responsables de la reacción, como las infecciones por virus, no estén presentes en el momento de realizar las pruebas epicutáneas.
El reordenamiento fue negativo en los casos 1 y 3, mientras que en el caso 2 no se pudo realizar. En general, en los casos de seudolinfomas inducidos por fármacos, se encuentra un reordenamiento policlonal del gen del TCR, aunque en algunas ocasiones puede ser monoclonal, por lo que no siempre se debe etiquetar el reordenamiento monoclonal como linfoma 17. En uno de los trabajos ya comentado 13, de los 8 casos de seudolinfoma sólo en uno fue positivo el reordenamiento del gen del receptor Tg. De hecho, el análisis molecular no puede establecer claramente el diagnóstico diferencial entre seudolinfoma y linfoma. La clínica, la histología y los análisis moleculares son esenciales, pero el criterio principal es la resolución de las lesiones con la suspensión del fármaco 17.
Aunque el mecanismo exacto del desarrollo de los seudolinfomas es desconocido, se cree que los fármacos actúan como antígenos produciendo un estado alterado en la inmunidad con depresión de la supresión de la función de los linfocitos T 18. Magro et al 19 han planteado la hipótesis de que los infiltrados de los seudolinfomas inducidos por fármacos están representados por una expansión no reprimida de linfocitos T de memoria activados, CD7 y CD62K negativos, en respuesta a los estímulos antigénicos.
Declaración de conflicto de intereses
Declaramos no tener ningún conflicto de intereses.
Correspondencia:
Yolanda Delgado. Servicio de Dermatología.
Hospital Universitario La Princesa.
Diego de León, 62. 28006 Madrid. España.
ydelgado@aedv.es
Recibido el 28 de junio de 2005.
Aceptado el 21 de diciembre de 2005.